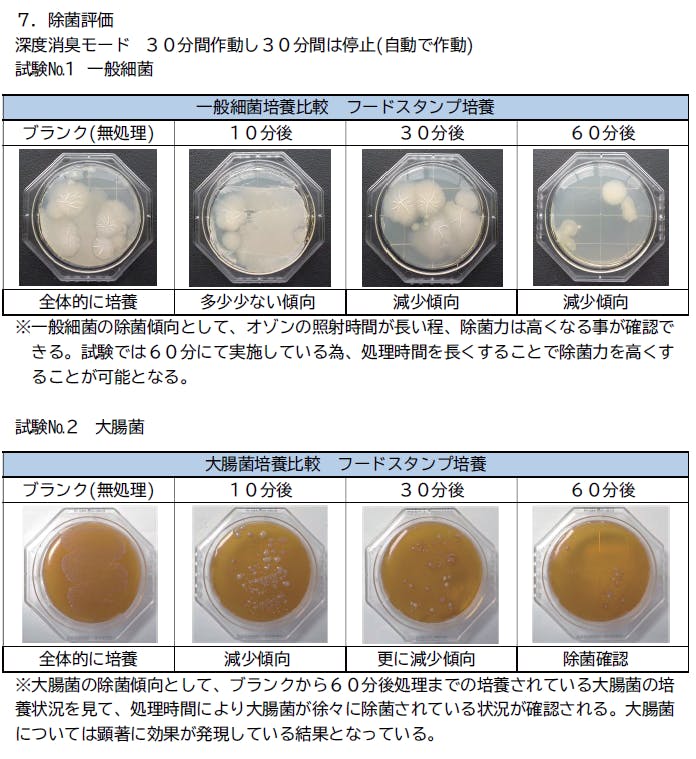
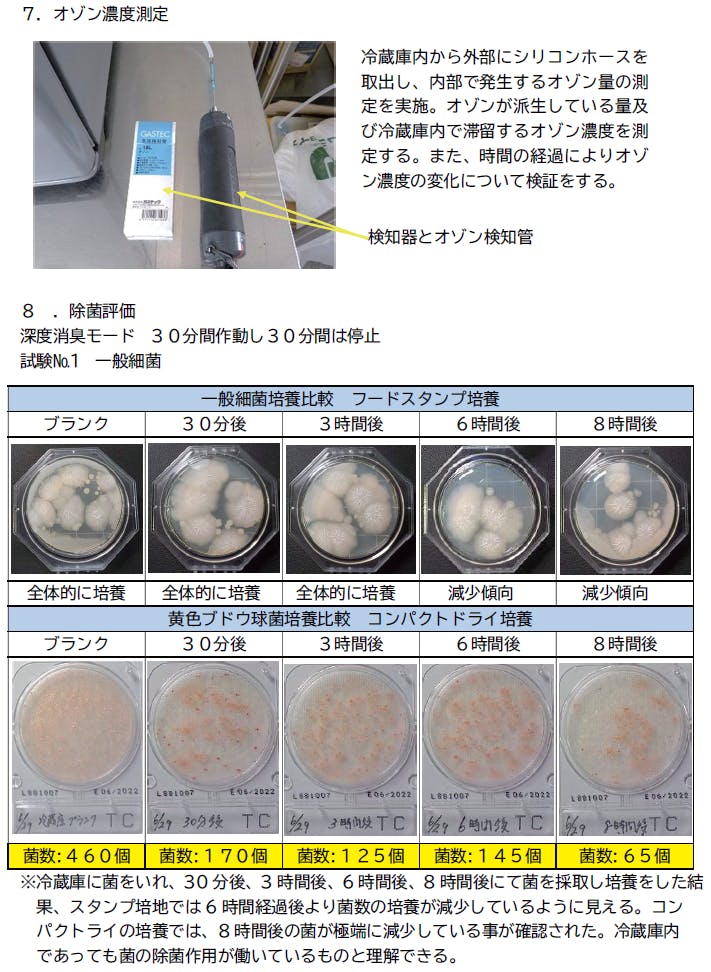
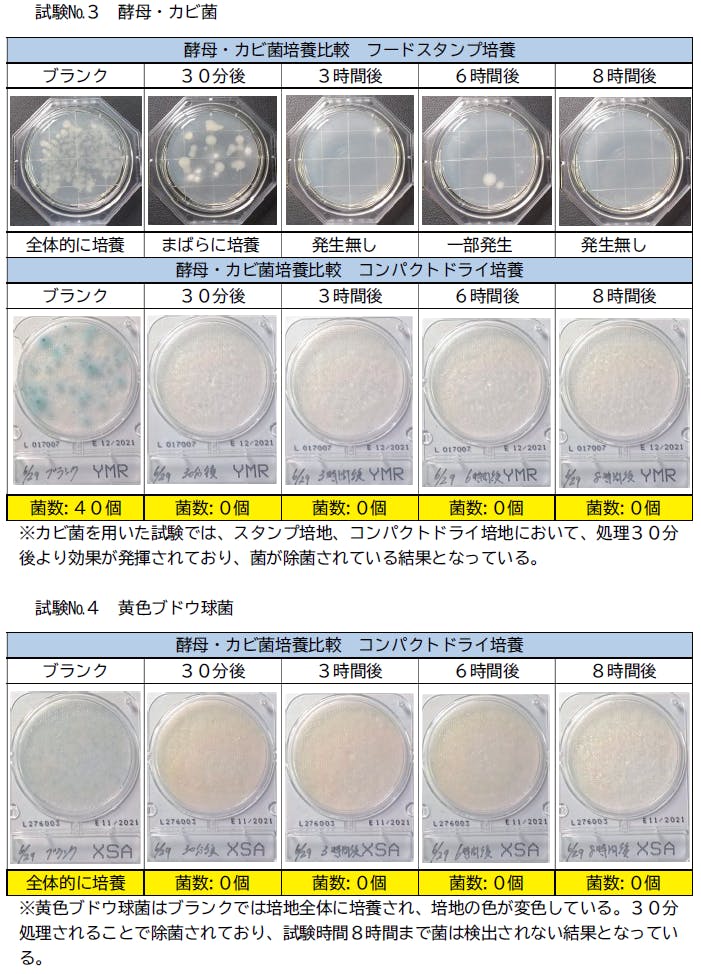

冷蔵庫を開けたときに感じる、なんとも言えない嫌なニオイ。
食材を扱う冷蔵庫がくさいのは、正直嫌ですよね。
・冷蔵庫の臭いにおい、気にはなるけど
・掃除する時間がない
・食材を腐らせてしまった
etc...
食品を新鮮に保つのに欠かせない冷蔵庫内では、様々な食材のニオイが充満。
とくに梅雨時や夏場は食材が傷みやすなりがち。
ドアを開け閉めする頻度が高くなるので温度が上がりやすく、 ニオイも発生しやすくなります。



オゾン発生消臭器『ne0clear(ネオクリア)』 は、コンパクトだけどパワフル。
ボタンひとつの簡単操作で、「鮮度保持モード」と「ハイパワー消臭モード」の2つのモードを搭載。
ニオイを香りなどでごまかす消臭方法とは異なり、ニオイや細菌のもとにオゾンが反応し除去します。


そもそもオゾンとは地球を取り巻く大気中のオゾン層に多く存在する気体で、大気中にあるオゾンは有害な紫外線を吸収して生命を保護する役割を果たしています。
空気中にもオゾンは微量に存在しており、大気を浄化する性質があるといわれています。
オゾンの化学式はO₃。酸素原子3つからできているので、酸素の同素体です。
オゾンによる分解イメージ
オゾン分子を形成する3つの酸素原子=O₃は、酸素(O₂)と比較するとかなり不安定であるという特性を持っています。
そのため、オゾンは菌やにおいの物質が近くにあると、酸素原子3つのうち1つを分離させて酸素(O₂)になろうとします。一方、菌やにおいの物質はオゾンの酸素原子と融合することにより酸化させられ分解されます。
除菌・脱臭が行われた後は酸素だけが残るだけになるので、きわめて安全性が高いといわれています。


冷蔵庫の中には、実は約700種類以上の細菌が存在していると言われています。
ある調査機関が調査を行ったところ、家の中でもっとも汚いところは浴室の密封ゴム、その次に冷蔵庫であると発表しました。
普段口にしている食材を保管している冷蔵庫内がニオイや菌であふれている・・・。
私たちの健康は大丈夫なのか、心配になりますよね。


「ne0clear」は消臭・除菌・鮮度保持・残留農薬分解の
4in1機能で冷蔵庫の環境と食材の鮮度を保ち、家族の健康を守ります。


オゾンのメカニズムを利用してどれほどの効果があるのか、 消臭、除菌、鮮度保持の実証試験を行い、
「ne0clear」の実力を実証します。




検査実施機関名:(株)富士計器 企画開発室/検査値:日本(北海道)/検査実施時期:2021年6月25日
権威機関による殺菌認証試験結果。殺菌率や約99.9%
『 消毒技術規範 』 ( 衛生部 2002 版 ) -2.1.5.7評価規定 ( 殺滅対数値平均 ≧3.00 )に合格し、
当該サンプルは検測細菌に対しての殺菌で合格。 ※すべての菌を除菌できるわけではありません。

検査実施機関名:(株)富士計器 企画開発室/検査値:日本(北海道)/検査実施時期:2021年6月30日

検査実施機関名:(株)富士計器 企画開発室/検査地:日本(北海道)/検査実施時期:2021年7月1日






検査実施機関名:(株)富士計器 企画開発室/検査地:日本(北海道)/検査実施時期:2021年7月1日
においの気になるところに自由に置けるので、好みに合わせて使うシーンを選べます!
※高温になる場所(夏場の車内など)や、水のかかる恐れのある場所では
使用しないでください。
お部屋
下駄箱
おもちゃ箱
クローゼット




シルバー
ピンクゴールド
パールグリーン
商品名:ne0clear[ネオクリア]充電式オゾン発生消臭器
本体サイズ:約125×33×34mm
本体重量:約77g
定格電圧:5V
定格電流:1A
定格出力:2W
電池容量:800mAh
電源方式:USB充電(Type-C)
付属品:オゾン発生器本体、フック、取扱説明書(日本語)、USB Type-C充電コード

Q.水の中でも使えますか?
A.耐水性ではございませんので、水気のないところでご使用ください。また、高温多湿を避けてご使用ください。
Q.オゾンは無臭ですか?
A.人によって感じ方は様々ですが、オゾン特有の香りがすることもあります。
Q.オゾンは人体に影響ないですか?
A.「ne0clear」のオゾンの発生濃度は20mg/㎡、すなわち0.02mg/Lなので人体の健康に影響はなく、安全です。また、オゾンは水や食品中に長期間存在しないので、残留することもありません。
Q.フィルター交換は必要ですか?
A.フィルターは使用しておりませんので、交換の必要はありません。お手入れも簡単でボタンひとつですぐに使えます。
Q.保証してくれますか?
A.お買上げ日より1年間の保証がございます。尚、保証期間内でも次の場合には有償修理となります。
①使用上の誤り、および改造や不当な修理による故障および損傷。
②お買上げ後の輸送・移動・落下により故障および損傷。
③火災、地震、水害、落雷、その他天災地変による故障および損傷。
④一般家庭以外でご使用されて生じた故障および損傷。
⑤本書のご提示がない場合、または本書の必要事項が記入されていない場合。
Q.冷凍庫で使えますか?
A.ある程度のマイナス温度には耐えられる設計にはなっておりますが、推奨はしておりません。
Q.充電時間の目安とモード別での使用可能時間を教えてください。
A.充電時間は約2時間です。「鮮度保持モード」で約20-25日間、「ハイパワー消臭モード」で約30時間ご使用出来ます。尚、充電残量が10%未満になった場合、赤色ランプが点滅してお知らせいたします。
【スケジュール】
2022年1月中旬 クラウドファンディング公開
|
2022年2月末日 クラウドファンディング終了
|
2022年3月上旬 リターン発送
【メーカーについて】
初めまして!NEOFRONTIERと申します。
弊社は創業12年目の生活用品全般を企画製造しているメーカーです。
みなさまの生活に寄り添い、少しでも日常のお手伝いが出来ればと日々努力しております。
今回のプロジェクトを通して、支援してよかったと思っていいただけるような喜ばれる商品をお届けしてまいります。
プロジェクト成功を想定し募集期間終了後すぐにお届けできるように現在計画中ですが、配送作業に伴う事情によりお届けが送れる場合がございます。 その際には迅速に活動レポートなどで随時共有を行っていく所存です。
【立ち上げたきっかけ】
数ある電化製品の中でも、冷蔵庫に関するオプションやメンテナンスのアイテム数は、実はそんなに多くありません。冷気を閉じ込めるために密封された空間の中には、様々な食材のニオイや雑菌が充満しています。そんな冷蔵庫内をクリーンに保ち、食材の品質を保つことで、"家族の健康を守れる"。そんな商品を世の中に広めたい!そういった思いからオゾン発生消臭器「ne0clear」のプロジェクトを立ち上げました。
【資金の使い道】
みなさまよりご支援いただきました資金は、今後【biji-ビジ-】シリーズのラインナップ拡大に向けての開発費用に充てたいと考えております。
【リターンについて】
CAMPFIREだけの特別価格で先行販売いたします。
新製品が発売前にいち早く手元に届くチャンスです。お見逃しなく!
<募集方式について>
本プロジェクトはAll-in方式で実施します。目標金額に満たない場合も、計画を実行し、リターンをお届けします。
最新の活動報告
もっと見る商品の発送が完了いたしました!
2022/03/04 16:28ご支援者の皆様、こんにちは!本日、すべての商品の発送が完了いたしましたのでこちらからお知らせいたします!!商品がお手元に届くまで今しばらくお待ちくださいませ。なお、発送方法につきましてはヤマト運輸、宅急便コンパクトでお送りしております。商品ご到着後、選択したカラーとお間違いがないか、また破損などの不良箇所がないかをよくご確認いただければと思います。※充電式オゾン発生消臭器「ネオクリア」を実際にご使用している様子や効果などご自身のSNSアカウントでもご紹介いただければ嬉しいです!!今後も皆様の生活に寄り添えるような商品の企画とご提案に尽力してまいります。第3弾も乞うご期待ください!最後になりましたが、本当に最終日まで温かいご声援とご支援、そして拡散をありがとうございました!!株式会社NEOFRONTIER チームメンバー一同 もっと見る
【御礼】クラウドファンディングが終了いたしました。
2022/03/01 15:56サポーターの皆様充電式オゾン発生消臭器「ネオクリア」への応援、ご支援、いつもありがとうございます。2月28日をもちまして今回のプロジェクトが終了となりました。おかげさまで、支援総額が826,680円に達して、目標金額達成率275%と、目標を大幅に上回る事ができ大変嬉しく思っております。改めまして、117名のサポーター皆様、ご支援いただき心よりお礼申し上げます。さて、出荷のスケジュールについてご報告いたします。リターン品につきましては皆様のお手元に早くお届けできるよう、発送の準備を進めてまいります。近日中に順次発送し、2週間以内には皆様のお手元に届く見込みです。今しばらくお待ちいただけますと幸いです。今後の発送準備等、進捗状況は活動報告で報告させていただきます。引き続き、充電式オゾン発生消臭器「ネオクリア」 をよろしくお願いいたします。株式会社NEOFRONTIER チームメンバー一同 もっと見る
【御礼】ネクストゴール②、ご支援者数100名様突破☆
2022/02/28 13:14皆様こんにちは!活動報告担当、濵平です!!ネクストゴールの200%を達成後、更なるネクストゴールとなるご支援者数100名様を突破いたしました( ゚Д゚)総支援額80万円を達成中です( ゚Д゚)☆すべてはご支援くださいました皆さまのおかげです。本当にありがとうございます…!!私自身の話になりますが、初のクラウドファンディングということもあり手探りでスタートした今回のプロジェクト。不安有り、しかし期待有り!という状態でこれまでやってきました。皆様からのご支援と温かい応援のおかげで無事に目標を達成することができました。そんな今回のクラウドファンディングも、残すところあと10時間となりました。応援コメントもたくさんいただいており、皆さまのリアルな声が聞けるのは非常に良い励みになっております。今後も皆さまに喜んでいただける商品をご提案できればと考えております。最後に、ご支援忘れや追加のご支援等はございませんでしょうか? クラウドファンディング終了後は、原則ご支援を承ることはできかますので、今一度ご確認のほどよろしくお願いいたします。残りわずか数時間ですが、商品拡散にもご協力いただければ幸いです。また、ご意見やご質問、気になる点等ございましたら、プロジェクト「お問い合わせ」ボタンより対応させていただきます。いつでもお気軽にご連絡くださいませ。引き続きよろしくお願いいたします。株式会社NEOFRONTIER チームメンバー一同 もっと見る






コメント
もっと見る